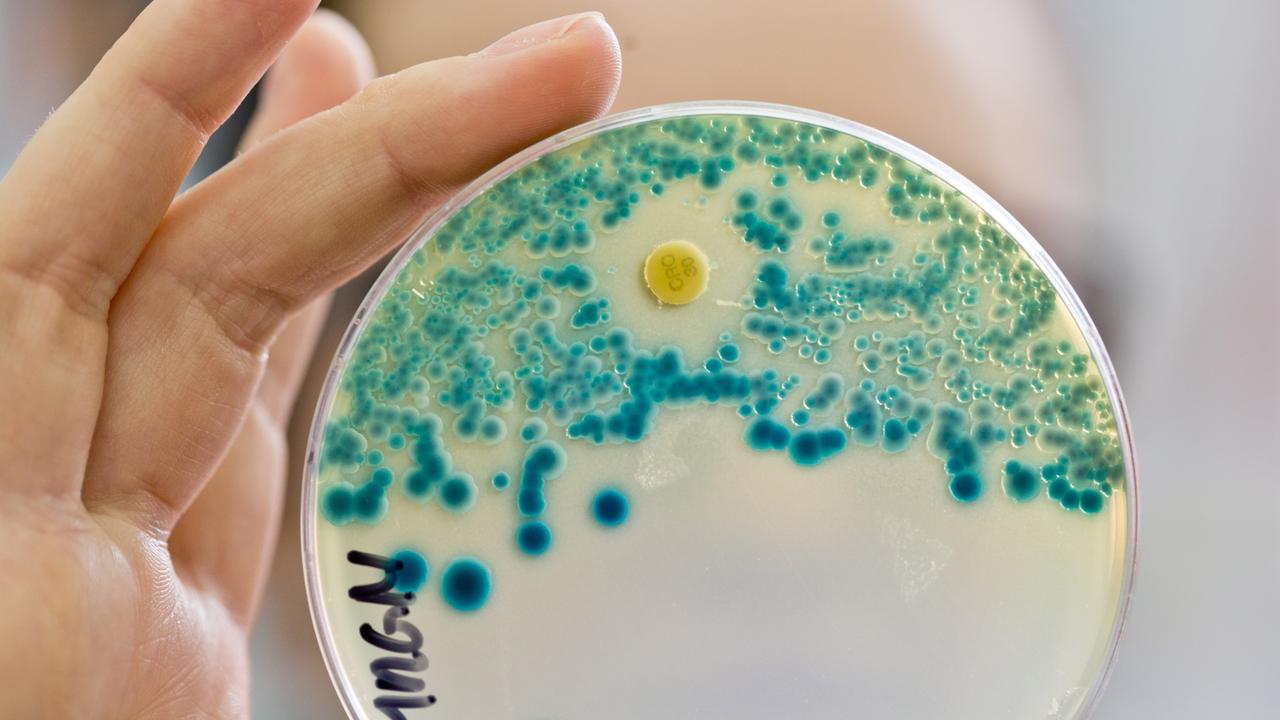
Diabetes: kuinka antibiooteille vastustuskykyiset bakteerit vaikeuttavat tämän sairauden aiheuttamien infektioiden hoitoa.

Tutkijat sekvenssoivat 10 maassa potilaita vaivaavien patogeenien kantojen genomit. Miksi tulokset viittaavat yksilöllisempien hoitostrategioiden tarpeeseen?
Sisältö
Diabeettinen jalka on krooninen komplikaatio, joka voi kehittyä diabeetikoilla. Se syntyy, kun hermovauriot ja verenkierron ongelmat yhdistyvät. Se voi johtaa haavaumiin, infektioihin tai jalkakudosten vaurioitumiseen, ja amputaation riskiin, jos hoitoa ei aloiteta ajoissa.
Brittiläinen tutkijaryhmä on havainnut, että diabeettisissa jalkainfektioissa esiintyy suurta geneettistä vaihtelua Escherichia coli -bakteereissa.
He ovat jopa löytäneet useita antibiooteille resistenttejä kantoja, eli niin sanottuja superbakteereja.
Tämä löytö pakottaa meidät miettimään uudelleen diagnoosia ja hoitovaihtoehtoja, jotta voimme estää potilaiden tilan huonontumisen.
Microbiology Spectrum -lehdessä julkaistu tutkimus osoitti, että Escherichia coli -bakteeria ei ole vain yhtä lajia, vaan useita kantoja, jotka pystyvät selviytymään ja sopeutumaan diabeettisiin jalkahaavoihin.
Tällainen patogeenien monimuotoisuus tarkoittaa, että potilaat tarvitsevat yksilöllisempiä hoitostrategioita.
Tutkimuksen tekivät tutkijat Lontoon Royal Collegesta ja Westminsterin yliopistosta Yhdistyneessä kuningaskunnassa .
Tutkimuksessa käytettiin näytteitä diabeettisen jalan potilaista Nigeriasta, Ghanasta, Ruotsista, Malesiasta, Kiinasta, Etelä-Koreasta, Brasiliasta, Intiasta ja Yhdysvalloista .

Kroonisten haavojen genomi
Diabeettinen jalka johtuu hermoston ja verenkiertoelimistön vaurioista, jotka heikentävät herkkyyttä ja estävät haavojen paranemista.
Infektioriski kasvaa ja sairaus voi edetä nopeasti. Jos hoitoa ei anneta ajoissa, amputaatio voi olla tarpeen.
Tutkijat halusivat selvittää, aiheuttavatko tietyt Escherichia coli -bakteerikannat vakavampia tai pysyvämpiä infektioita diabeettisessa jalassa.
Tätä varten sekvensoitiin 42 kannan täydelliset genomit, jotka oli eristetty infektoituneista haavoista potilailla eri maissa.
Analyysin avulla voitiin verrata patogeenisiä mikro-organismeja kunkin potilaan kohdalla ja tunnistaa antibioottiresistenssigeenit.

Monipuolinen ja monimutkainen bakteerien maailma
Tutkijaryhmä analysoi 42 Escherichia coli -näytettä, jotka oli otettu haavoista kymmenen maan sairaaloissa. He tunnistivat seitsemän fylogeneettistä ryhmää ja 28 sekvenssityyppiä, mikä heijastaa merkittävää geneettistä monimuotoisuutta.
Pangenomisen analyysin tuloksena eroteltiin yli 18 000 geeniryhmää, joista vain 2400 oli läsnä kaikissa kannoissa ja yli 11 000 oli ominaisia vain joillekin eristetyille kannoille.
78 % eristetyistä kannoista luokiteltiin moniresistenteiksi tai erittäin resistenteiksi.
Löydettiin geenejä, jotka takaavat resistenssin laajalti käytettyjä antibiootteja vastaan ja joissakin tapauksissa myös viimeisen keinon lääkkeille, kuten kolistiinille ja karbapeneemeille.
Ei ole olemassa yhtään antibioottia, joka olisi tehokas kaikkia testattuja kantoja vastaan, mikä vaikeuttaa näiden infektioiden hoitoa.
Lisäksi on löydetty geenejä, jotka edistävät bakteerien tarttumista kudoksiin ja immuunijärjestelmän kiertämistä, mikä selittää monien diabeettisen jalan infektioiden sitkeyden ja vakavuuden.
Tutkimus osoitti myös, että bakteereilla on yhteisiä perusmetaboliittisia toimintoja, mutta niissä on eroja, jotka edistävät niiden sopeutumista erilaisiin olosuhteisiin haavassa.
Ennaltaehkäisy, hoito ja uudet menetelmät.
Diabeettisen jalan paras ennaltaehkäisy sisältää potilaiden kouluttamisen, itsenäisen hoidon, sopivien jalkineiden käytön ja jalkojen säännöllisen tarkastamisen vammojen tai muutosten varalta.
Säännölliset kliiniset tarkastukset ja riskitekijöiden varhainen tunnistaminen ovat tärkeitä haavojen ja infektioiden ennaltaehkäisyssä.
Brittiläiset tutkijat ovat suositelleet genomiseurannan ja mikrobilääkeresistenssin seurannan lisäämistä diabeettisen jalan diagnoosiin ja hoitoon.
Pikamolekyylitestit voisivat parantaa antibioottien valintaa ja vähentää vakavien komplikaatioiden riskiä.
Infobae-lehden haastattelussa tohtori José Daniel Braver, D-Foot International -järjestön koordinaattori Latinalaisessa Amerikassa ja diabeettisen jalan hoito-ohjelman johtaja, selitti: ”Uusi tutkimus, joka on julkaistu Microbiology Spectrum -lehdessä, kuvaa suoliston ulkopuolisia Escherichia coli -bakteereja, jotka aiheuttavat vakavia komplikaatioita joissakin matalan ja keskitulotason maissa, joissa sairaalainfrastruktuuri on puutteellinen. Ne voivat aiheuttaa vakavia komplikaatioita, kuten vaikeita diabeettisen jalan infektioita. Tällaiset infektiot ovat hyvin yleisiä ihmisillä, joilla on huonosti hallittu diabetes .”
Asiantuntijan mukaan diabetesta sairastavan potilaan, jolla on jo infektoitunut haavauma, hoito tulee suorittaa useiden asiantuntijoiden tiimi, mukaan lukien infektiolääkäri.
”Antibiootteja ei tule määrätä ilman, että haava on ensin puhdistettu huolellisesti ja otettu näyte bakteriologista tutkimusta varten taudinaiheuttajan tunnistamiseksi. Kun taudinaiheuttaja on tunnistettu, on aloitettava asianmukainen antibioottihoito”, hän totesi.
”Antibioottien empiirinen käyttö on vakava virhe, koska se edistää resistenssin kehittymistä”, varoitti Braver, joka on diabeteksen jalkojen hoidon komitean (SAD) jäsen.
Lisäksi lääkärin vastaanotolla on arvioitava huolellisesti haavan syvyys ja selvitettävä, ulottuuko se jo luuhun, koska tämä vaikuttaa antibioottien määräämisen ajankohtaan”, hän selitti.
On myös tärkeää selvittää, onko potilaalla alaraajojen iskemia. On tarpeen suorittaa ankel-olkapää-indeksi (API) -testi, joka on ei-invasiivinen testi, jossa verrataan nilkan ja käden verenpainetta jalkojen verisuonten tukosten havaitsemiseksi.
”Joissakin tapauksissa potilas tarvitsee sairaalahoitoa. Näin voi käydä, jos kehittyy infektio, joka vaatii kirurgista dreenausta. Sairaalahoito on tarpeen myös, jos potilaalla on iskemia ja infektio”, hän sanoi. Kaikkia sairaalahoitoon otettuja potilaita tulee seurata diabeteksen jalkojen hoitoon erikoistuneiden asiantuntijoiden ryhmä.
”Nykyään on erittäin tärkeää kouluttaa perusterveydenhuollon lääkäreitä tunnistamaan ajoissa potilaat, joilla on tämä diabeteksen komplikaatio, ja ohjaamaan heidät asiantuntijoiden hoitoon. Meidän on muistettava, että aika on kudosta. Mitä aikaisemmin hoito aloitetaan, sitä vähemmän kudosta menetetään”, hän korosti.
